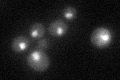
YNL097C
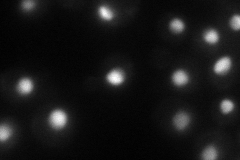
YNL097C
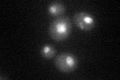
YNL097C

View description
Probable component of the Rpd3 histone deacetylase complex, involved in transcriptional regulation of PHO5; C-terminus has similarity to human candidate tumor suppressor p33(ING1) and its isoform ING3
Localization:
Intensity:
Fold change:
Significance:
-
C’ GFP library in SD
nucleus28.98 -
N' NOP1pr-GFP in SD
nucleus53.2186 -
N' TEF2pr-mCherry in SD

nucleus52.9645 -
N' NATIVEpr-GFP in SD

nucleus37.6917 -
N' TEF2pr-VC and Cyto-VN in SD

punctate,nucleus26.3929 -
C’ GFP library in SD+DTT
nucleus26.870.92No -
C’ GFP library in SD+H2O2

nucleus32.081.1No -
C’ GFP library in Starvation Media

nucleus39.261.35Yes -
C’ GFP library on the background of Pup2-DaMP

N/A -
C’ GFP library on the background of CCT mutant

N/A0N/AYes
